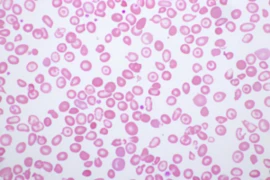

Mathilde Granger
DVM, Dip A.Phys, MRCVS Vet Physio.

Mathilde Granger
DVM, Dip A.Phys, MRCVS Vet Physio.
Mathilde qualified as a vet in 2002 in France (National Veterinary School of Alfort). She passed her Intership in small animal medicine and surgery at the same Vet School, and continued to study in surgery there for another year. After this specialisation, she worked as a general small animal practitioner in France and in the UK until she decided, in 2009, to specialise in physiotherapy and rehabilitation. She passed the exam for the Diploma of Animal Physiotherapy with The College of Animal Physiotherapy in October 2012. Building up on this, she developed the rehabilitation centre in association with the hydrotherapy unit and the pain clinics at Langford Vets, Small Animal Hospital for the University of Bristol. Since 2016, she has created Vet&Physio Ltd, a private small animal physiotherapy and rehabilitation centre based in Somerset, UK. She is currently studying acupuncture and integrated care, to support even better our beloved pets in their late years.
Webinare

Mathilde Pluim
DVM, PhD, Dipl.ECVSMR, FEI-Teamtierarzt am Steuer in Deutschland

Mathilde Pluim
DVM, PhD, Dipl.ECVSMR, FEI-Teamtierarzt am Steuer in Deutschland
Mathilde Pluim ist eine europäische Spezialistin für tierärztliche Sportmedizin und Rehabilitation und promovierte an der Universität Gent über die Wirksamkeit der High-power laser bei der Behandlung von Sehnenverletzungen bei Pferden. Mathilde Pluim ist auch Teamtierärztin des deutschen Fahrerteams und offizielle FEI Tierärztin. Sie arbeitete 12 Jahre in der Tierklinik Lüsche in Deutschland und sammelte umfangreiche Erfahrungen in Orthopädie und Sportmedizin. Sie war auch eine internationale Springreiterin. Ihre Spezialisierung, Forschung und Erfahrung haben sie zu einer Expertin auf ihrem Gebiet gemacht. Im TeamVet Centre NL, der niederländischen Praxis, die sie in Zusammenarbeit mit der Tierklinik Lüsche eröffnet hat, wird sie sich auf ihr Fachgebiet konzentrieren: Sportmedizin und Rehabilitation.
Webinare

Matija Medved
DVM

Matija Medved
DVM
Product Manager für DE/AT/CH bei Vetoquinol
Webinare

Matthew Garland
BSc, RSciTech, SAC DIP, Cert Nat Sci, VN, MRSB

Matthew Garland
BSc, RSciTech, SAC DIP, Cert Nat Sci, VN, MRSB
Matthew Garland is a Laboratory director and veterinary laboratory manager with over 20 years’ experience in the veterinary field.
Matthew is passionate about all things laboratory and has a keen interest in QA/QC and haematology. Matthew has also contributed to several published research projects. Holding a degree in chemistry and molecular biology he is a qualified Veterinary Nurse, a registered Science technician with the Royal society of biology (RSB) and holds various post graduate certificates.
Currently working for VPG (The veterinary Pathology group) he also enjoys his time as a lecturer teaching student veterinary nurses the laboratory skill. Matthew also delivers regular CPD and has also been lucky to present at all the major UK congresses (BSAVA, BVNA and LVS) as well as having several articles published on veterinary haematology and clinical biochemistry.
Being passionate about team development and the development of others Matthew sits on the registers assessors board of the RSB and is also a judge for the RSB biology apprentice of the year.
Webinare

Matthew Gosbell
BVSc, MANZCVS (Avian Health), AAV

Matthew Gosbell
BVSc, MANZCVS (Avian Health), AAV
Matthew graduated from the University of Melbourne in 1994. After graduation he worked in mixed dairy practice in Victoria before traveling to the UK. In 2003 he took on a Veterinary Director position at Springvale Animal Hospital in Victoria. In 2005 he started started casual teaching cage and aviary medicine and surgery at Melbourne University, he now lectures and runs severe practical classes for the University. He acquired membership to the Australian College of Veterinary Science in 2008. Since then he has regularly given lectures, workshops and webinars to qualified veterinarians and has authored and co-authored peer review papers.
Webinare

Matthias Le Chevoir
DVM, Dip ECVN

Matthias Le Chevoir
DVM, Dip ECVN
Matthias graduated from the Ecole Vétérinaire d’Alfort (France) in 2006. Following awarding of his DVM, he completed a general rotating internship followed by a medicine internship in the same institution. He then was accepted to take a neurology residency program in the same institution which he completed between 2008 and 2011. He was awarded the title of diplomate of the European College of Veterinary Neurology (DipECVN) by examination in October 2011.
He has been working as a lecturer in neurology and neurosurgery at the University of Melbourne since then. He is providing lectures to the students as well clinical supervision for the residents. He also directly consults at U-Vet.
His field of interest are neuro muscular disease ; canine idiopathic polyradiculoneuritis (Coonhound paralysis) specifically. He also has strong interest in idiopathic epilepsy and non-infectious inflammatory disease of the central nervous system in dogs (meningo-encephalitis of unknown origin, granulomatous meningo-encephalitis and necrotising meningo-encephalitis) and optimising the treatment and follow-up of such conditions.
He has research programs on idiopathic polyradiculoneuritis in dogs, implantable EEG devices, meningoencephalitis of unknown origin and brain tumours of dogs and future perspectives in this field. He has been involved in new devices for the control of seizures in dogs with idiopathic epilepsy.
He has given talks in France, Great Britain, China and Australia and regularly publishes in the field of veterinary neurology.
Webinare

Matthias Seewald
DVM

Matthias Seewald
DVM
Geboren 1981
2002-2008: Studium an Vetmeduni Wien und Vetsuisse Bern
2008: Assistenzarzt in Gemischtpraxis in Schweden
2008-2011: Doktorat an Vetmeduni Wien
2009-2010: Assistenzarzt in TK, Schwarzmann, TK Imst
2011: Hospitanz in Zoo Hellabrunn und TP Berlin
Seit 2012: eigene Tierarztpraxis
Gründungs- und Vorstandsmitglied der Österreichischen Gesellschaft für Tierärztliche Zahnheilkunde (ÖGTZ).
Host der ersten beiden Fachtagungen der ÖGTZ (2015+2016), sowie der 3.+4. Fachtagung (2017 +2018) und President des LOC des EVDF 2018 (european dental forum 2018) der europäischen Fachtagung für tierärztliche Zahnheilkunde (EVDS.org) jeweils in Innsbruck.
Webinare

Matthias Wieland
DVM, Dip. ECBHM, Assistant Research Professor

Matthias Wieland
DVM, Dip. ECBHM, Assistant Research Professor
Matthias Wieland ist auf einem Milchviehbetrieb in Süddeutschland aufgewachsen. Nach Abschluss einer landwirtschaftlichen Ausbildung, absolvierte er das tiermedizinische Studium an der Tierärztlichen Fakultät der Ludwig-Maximilians-Universität in München.
Nach Abschluss des Studiums im Jahr 2007, promovierte er an der Klinik für Wiederkäuer über Nabelerkrankungen beim Kalb. Nach der Fertigstellung der Dissertation war er bis 2013 als wisschenschaftlicher Mitarbeiter an der Klinik tätig.
Er absolvierte ein Residency-Programm und ist seit 2014 Diplomate des „European College of Bovine Health Management“. Das letzte Jahr des 3-jährigen Residency-Trainings absolvierte er an der „Ambulatory and Production Medicine Clinic“ an der Cornell Universität.
Im Jahr 2015 erhielt er ein Stipendium zur Forschung über die Zusammenhänge des Melkvorgangs und der Eutergesundheit bei Milchkühen.
Seit 2017 arbeitet er in der Bestandsbetreung bei „Quality Milk Production Services“.
Webinare

Max W. Mosing
DVM, LL.M.(IT-Law), LL.M.(Strathclyde)

Max W. Mosing
DVM, LL.M.(IT-Law), LL.M.(Strathclyde)
- Seit 2014
Partner GEISTWERT Rechtsanwälte;
Disziplinaranwalt-StV der Österreichischen Tierärztekammer - Seit 2013
Lehrauftrag beim postgradualen Universitätslehrgang für Informations- und Medienrecht der Universität Wien - 2009 bis 2014
Partner Gassauer-Fleissner Rechtsanwälte GmbH - Seit 2007
Regelmäßige Vortragstätigkeit bei WIFI Wien – Team IT Recht - 2006
Rechtsanwaltsprüfung, Wien - 2004 bis 2007
Rechtsanwaltsanwärter bei Gassauer-Fleissner Rechtsanwälte GmbH, Wien - Seit 2004
Lehrbeauftragter an University of Applied Sciences for Information & Knowledge Management, Eisenstadt;
Rechtsanwaltsanwärter bei Graf, Maxl & Pitkowitz Rechtsanwälte, Wien - 2001 - 2003
Rechtsanwaltsanwärter bei Rechtsanwalt Dr. Werner Mosing, Feldkirchen iK;
Postgraduales Studium “Telecommunications Law”, Strathclyde University, UK (LL.M.); Rechtsanwaltsanwärter bei Schönherr Rechtsanwälte OEG, Wien;
Postgraduales Studium “Informationsrecht und Rechtsinformation”, Universität Wien (LL.M.) - 1995 bis 2000
Universität Graz, Rechtswissenschaftliche Fakultät (Mag. iur. 2000; Dr. iur 2003)
Webinare

Maximilian Pagitz
DVM

Maximilian Pagitz
DVM
- 2006 Promotion an der Veterinärmedizinische Universität Wien. Thema: Evaluation of biological variance of cystatin C in comparison with other endogenous markers of glomerular filtration rate in healthy dogs.
- Seit 09/2002 Teilzeit und seit 04/2004 Vollzeit wissenschaftlicher Mitarbeiter an der Klinischen Abteilung für Interne Medizin Kleintiere der Veterinärmedizinischen Universität Wien.
- Arbeitsbereiche: Onkologie, Nephrologie, Endokrinologie.
- Seit 2010 zusätzlich medizinische Leitung der Nuklearmedizin in der Plattform für Radioonkologie und Nuklearmedizin der Veterinärmedizinischen Universität Wien.
Webinare

Maximiliane Haider
DVM, ECVIM-CA, EBVS

Maximiliane Haider
DVM, ECVIM-CA, EBVS
Diplomate des European College of Veterinary Internal Medicine (Dipl. ECVIM-CA)
EBVS® European Veterinary Specialist in Small Animal Internal Medicine
2005-2011 Studium an der Veterinärmedizinischen Universität Wien
2011-2013 Doktorat und Internship an der Medizinischen Kleintierklinik München (LMU)
2013-2016 Residency an der Universität in Gießen; Externships an der UC Davis (USA) und bei Dick White Referrals (UK)
2016-2021 Oberärztin für Innere Medizin in Kleitierklinken in Wien, Stockholm und der Schweiz.
2022 Konsillartieräztin für Innere Medizin und Ultraschall.
Mitgründerin des Vetklinikums, welches im Oktober in Wien eröffnet wird.
Webinare

Maya Bräm
DVM, Dipl. ECAWBM(BM)

Maya Bräm
DVM, Dipl. ECAWBM(BM)
Dr. Bräm schloss ihr Veterinärmedizinstudium im Jahr 2000 an der Universität Bern ab, worauf sie sich gleich im Rahmen ihrer Doktorarbeit und der ersten Verhaltensweiterbildung der STVV in der Schweiz auf die Verhaltensmedizin konzentrierte. Es folgte ein mehrjähriger Auslandaufenthalt in Lincoln (UK), bei dem sie mit Prof. Daniel Mills wissenschaftlich und in der Verhaltensklinik arbeiten durfte. Parallel dazu absolvierte sie eine Weiterbildung als Hundetrainerin, in Phytotherapie sowie in der manuellen Therapieform "Canine Bowen Technique". Zurück in der Schweiz forschte sie nebst der praktischen Arbeit im Bereich Verhaltensmedizin am Tierspital Zürich sowie in ihrer Privatpraxis im Bereich Hochsensibilität beim Hund. Nach ihrem 3-jährigen non-conforming Residency des ECAWBM(BM) in Verhaltensmedizin bestand sie Ende 2020 das European Board Exam und ist nun die erste Europäisch diplomierte Verhaltenstierärztin in der Schweiz. Sie arbeitet weiterhin in der klinischen Verhaltensmedizin am Tierspital Zürich und in ihrer Privatpraxis und arbeitet daran, die Forschung im Bereich "Sensory Processing Sensitivity" auch bei anderen Tierarten zu ermöglichen.
Webinare

Mayank Seth
DVM, European Veterinary Specialist in Internal Medicine

Mayank Seth
DVM, European Veterinary Specialist in Internal Medicine
Mayank qualified from the Royal Veterinary College, London, in 2004 and went on to spend two years in small animal general practice in the UK. Mayank undertook an internship at the Animal Health Trust in 2006 before moving to the University of Pennsylvania, Philadelphia, where he completed a residency in Small Animal Internal Medicine and a fellowship in Haematology and Transfusion Medicine. Mayank moved back to the UK in 2011 and has been working as a Small Animal Internal Medicine specialist since that time, becoming Head of Internal Medicine at The Animal Health Trust in 2013. Mayank is interested in all aspects of Small Animal Internal Medicine but his research focus is immunohaematology and transfusion medicine.
Webinare

Megan Brashear
BS, CVT, VTS (ECC)

Megan Brashear
BS, CVT, VTS (ECC)
Megan graduated in 2000 with a BS in in Veterinary Technology. She has worked in emergency and critical care since 2000 earning her veterinary technician credentials in 2000 and in 2004 became a Veterinary Technician Specialist in Emergency and Critical Care. Megan currently works as the Small Animal Nursing Manager at the Purdue University Veterinary Teaching Hospital in West Lafayette, Indiana, where she enjoys working with technician supervisors as well as teaching and training technicians and students on the hospital floor. She loves the opportunity to travel and lecture sharing her knowledge with veterinary technicians and nurses around the world.
Webinare

Megan Kelly
DVM, BVSc, Dip Vet, CCRP

Megan Kelly
DVM, BVSc, Dip Vet, CCRP
Megan is a qualified Veterinary Surgeon with a special interest in pain management and veterinary rehabilitation. She qualified in 2001 and spent 4 years in the UK practicing in mixed and small animal practices. In 2005 she studied Canine Rehabilitation and Physical Therapy at the University of Tennessee (Knoxville, USA) and Western Scientific Acupuncture through the British Veterinary Acupuncture Society.
In 2007 she opened the Holisticvet animal wellness centre, the first veterinary rehabilitation centre in South Africa.
In 2010 she developed her own range of rehabilitation products called Holisticpet and continues to develop new innovative products to assist handicapped pets.
She is actively involved in promoting veterinary rehabilitation in South Africa by lecturing to veterinary surgeons and veterinary nurses.